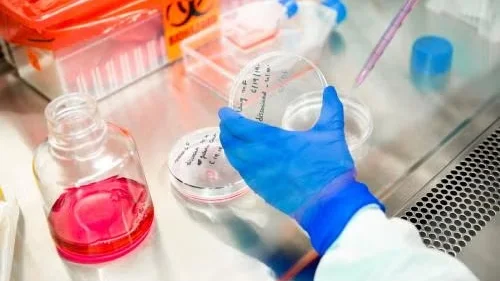
Gloved hand handling petri dish in lab with pipette, culture media, and biohazard container.

Stem Cell Bank
Broad Stem Cell Research Center (BSCRC)
Overview
The Stem Cell Bank facilitates culturing, storage and distribution of high-quality human embryonic and induced pluripotent stem cell lines to UCLA investigators who have obtained human pluripotent stem cell research oversight committee approval to conduct this research.
Mission
The mission of the human pluripotent stem cell bank is to:
- Ensure standardized scientific procedures and quality control of human pluripotent stem cell lines
- Provide the UCLA research community with critical research tools, including lines derived at other institutions under appropriate approvals
- Distribute human embryonic stem cells that are on the NIH Stem Cell Registry and eligible for research with federal funds
- Eliminate the unnecessary duplication of compliance oversight review by ensuring a single site, the stem cell bank, is responsible for receipt and distribution of lines to approved investigators
Leadership

Contact
Website: Stem Cell Bank